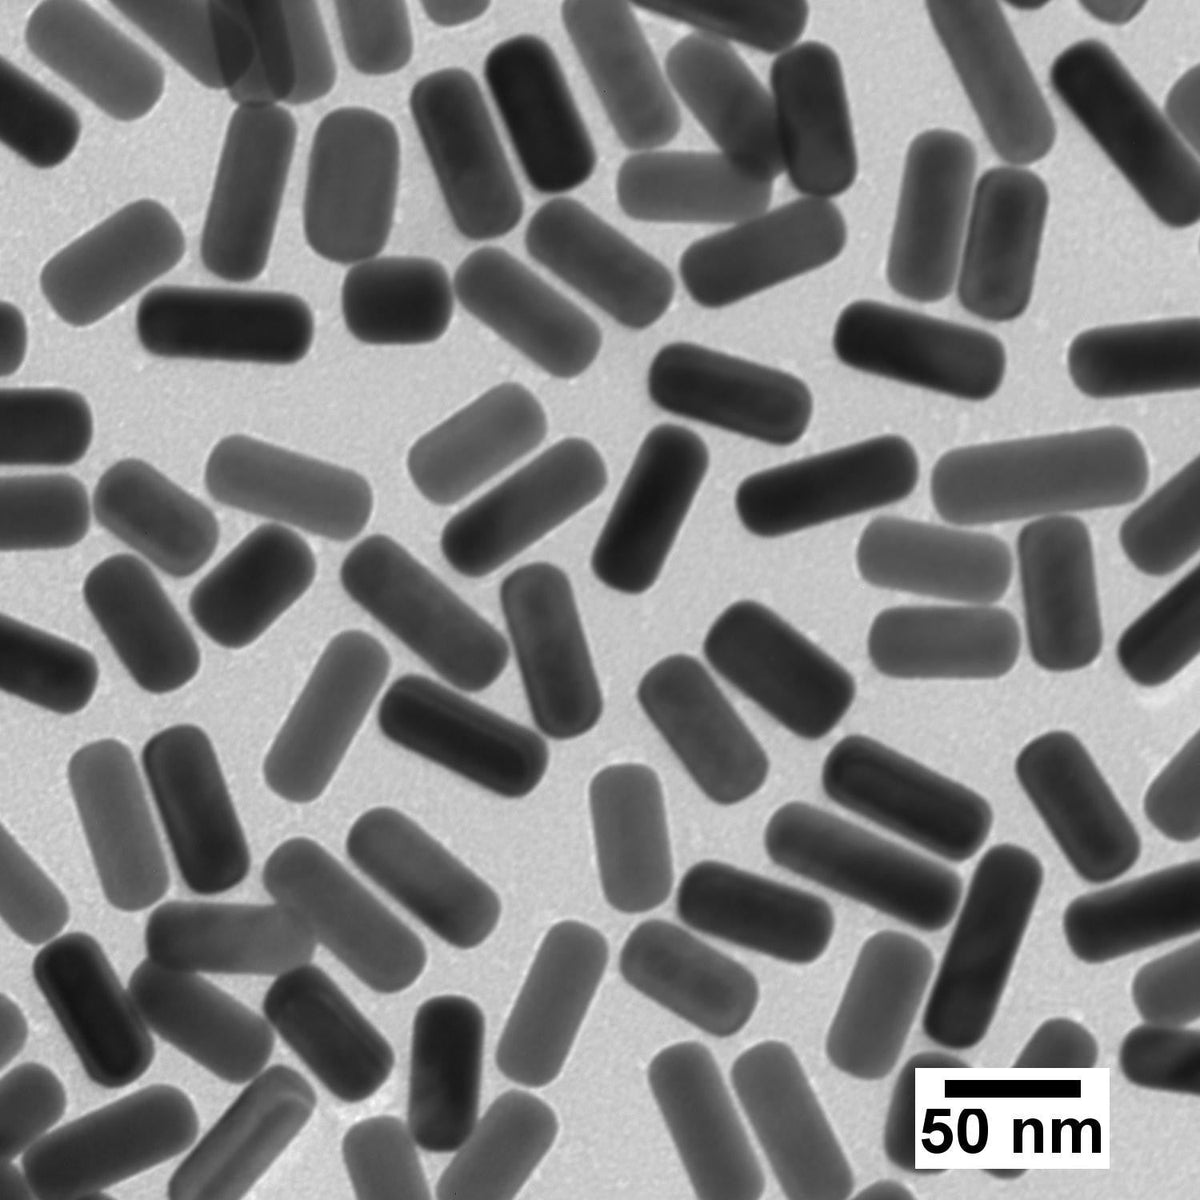
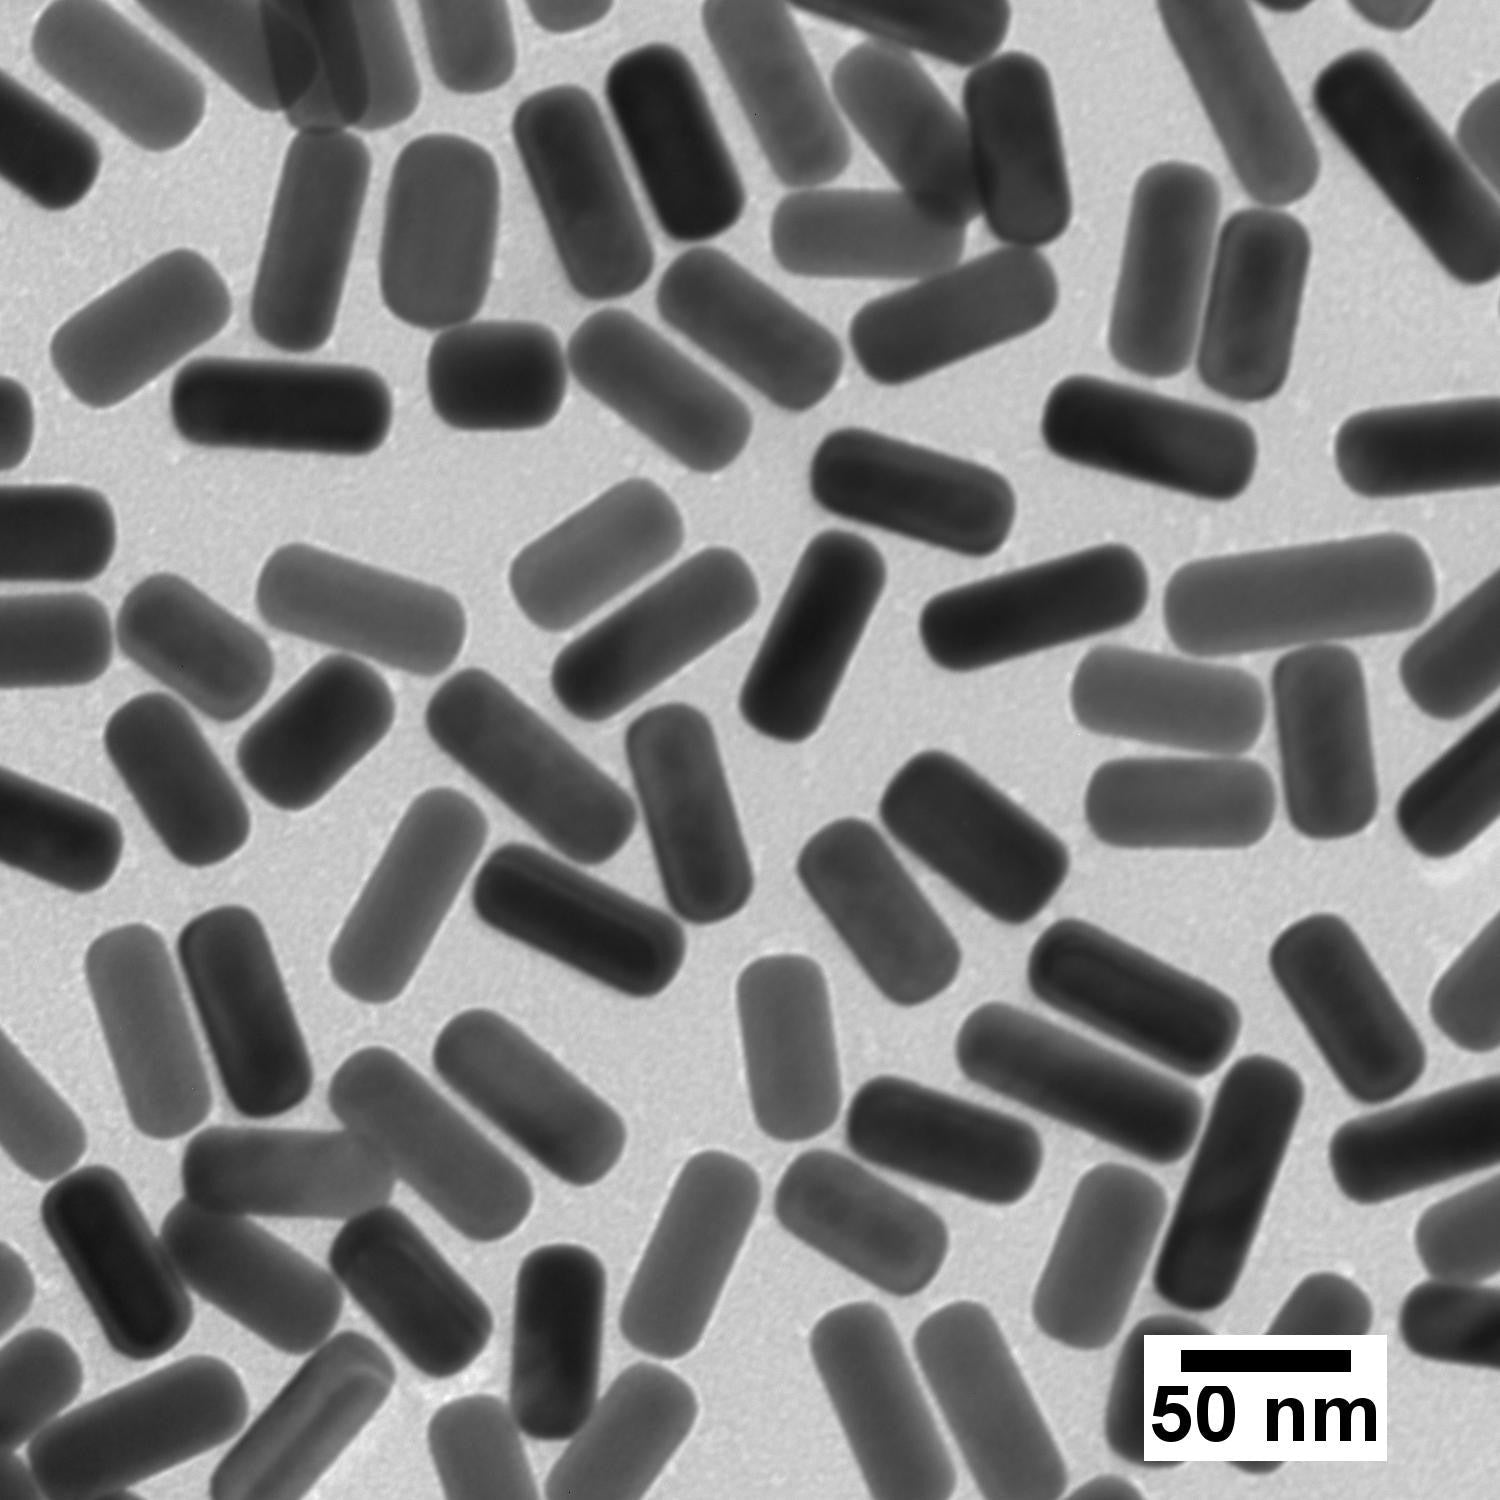

Peak λ 650 nm Gold Nanorods
Customers outside of the US & Canada: please visit your local distributor’s website to purchase this item using its SKU, or contact us here. Thank you!
As a global leader in gold nanoparticle production, nanoComposix specializes in providing high-purity and monodisperse nanomaterials – delivering the quality you need for consistent results.
650 nm peak resonance (SPR) gold nanorods combine strong plasmonic optical properties with unique anisotropic morphology. These nanoparticles are compatible with conventional 650 nm lasers and are useful in a broad range of applications from immunodiagnostics, biosensors, sensing, photothermal therapy, SERS, optical filters, and more.
nanoComposix provides high quality nanomaterials that are precisely engineered and highly characterized. All our products are supplied with a batch-specific Certificate of Analysis including characterization data such as TEM, DLS, Zeta, and UV-Vis.
Intended for Research Use Only. Not for use in diagnostic procedures. Contact us for custom formulations, ISO 13485/cGMP compliant materials, or bulk supply requirements.
| Overview | |||
|---|---|---|---|
| Surface | Citrate | PEG-Carboxyl | PEG |
| Description | Easiest standard surface to displace with other molecules. | Covalently bound. Conjugatable surface. | Highest stability in aqueous buffers and polar organic solvents. |
| Solvent | USP Purified Water | USP Purified Water | USP Purified Water |
| Surface chemistry | Citrate | PEG12-carboxylic acid | mPEG 5 kDa |
| Specifications | |||
| Surface | Citrate | PEG-Carboxyl | PEG |
| Peak wavelength (> 90% peak absorbance) | 650 nm | 650 nm | 650 nm |
| Typical aspect ratio | 2.7 | 2.7 | 2.7 |
| Typical length | 40 ± 15 nm | 40 ± 15 nm | 40 ± 15 nm |
| Typical thickness | 15 ± 5 nm | 15 ± 5 nm | 15 ± 5 nm |
| Documents | |||
| Surface | Citrate | PEG-Carboxyl | PEG |
| Example Certificate of Analysis (CoA) | Download | Download | Download |
| Storage & Handling | Download | Download | Download |
| Safety Data Sheet (SDS) | 1 OD (NanoXact) 50 OD (NanoXact) |
50 OD (NanoXact) | 50 OD (NanoXact) |
| Protocols | N/A | NanoXact Carboxyl Gold Nanorod Covalent Conjugation | N/A |
| Expected Ranges | |||
| Surface | Citrate | PEG-Carboxyl | PEG |
| Hydrodynamic diameter (DLS) | 5–25 nm | 5–25 nm | 5–25 nm |
| Zeta potential | ≤ –20 mV | ≤ –20 mV | ≤ –20 mV |
| pH of solution | 5.0–8.5 | 5.0–8.0 | 5.0–7.5 |